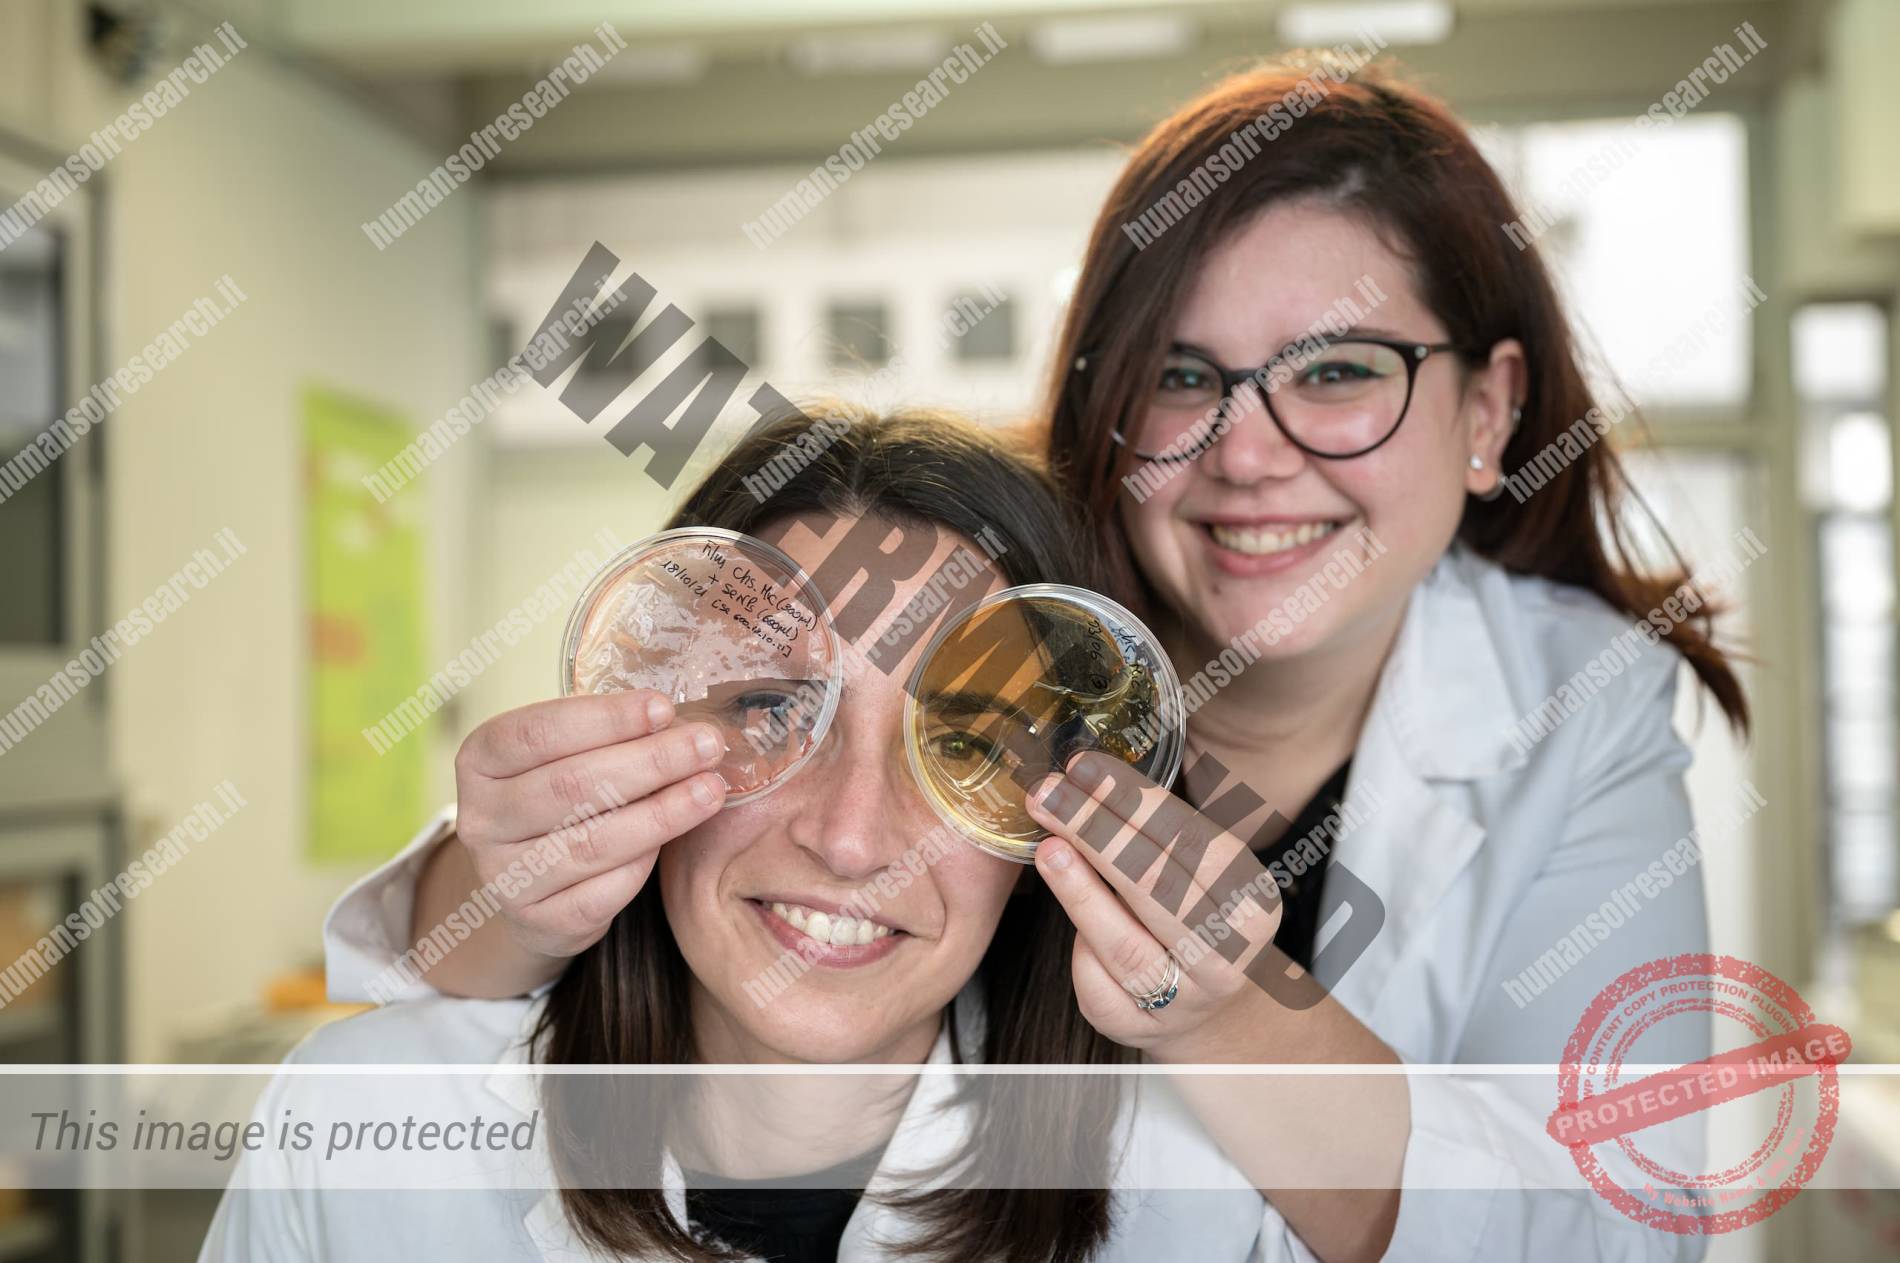

Elena Piacenza
Ricercatrice presso il Dipartimento STEBICEF dell'Università degli Studi di Palermo. Studia e sviluppa nuovi nanomateriali e nanocompositi eco e bio compatibili per protesi ortopediche che possano simultaneamente favorire la crescita ossea, evitare il rigetto della protesi stessa e prevenire l'insorgenza di infezioni acute e croniche.
 Verona vuol dire famiglia, a Venezia ho imparato lo spirito di adattamento mentre a Calgary la propensione al dialogo. Palermo invece è multiculturalità e accoglienza, aspetti fondamentali del mio lavoro da ricercatrice. ![]()
Per i fenici era Zyz cioè fiore, i greci si sentivano a casa, per gli antichi romani invece Panormus era considerata una “città-porto” ricca da sfruttare, il granaio dell’impero.
Balarm, l’eletta, per gli arabi. Un punto di riferimento al centro del loro dominio. Per i conquistatori del nord Europa come i Normanni e gli Svevi era il simbolo delle arance e del sole, ma anche un tassello strategico per l'espansione politica e soprattutto culturale.
Ma con l’avvento degli Aragonesi e successivamente dei Borboni la città subì un duro colpo che col passare del tempo la portò a diventare una lontana provincia da sfruttare.
Nonostante le avversità, soprattutto dal secondo dopoguerra in poi, Palermo e i suoi cittadini restano in piedi, doloranti e afflitti ma sempre in piedi e a testa alta, fieri del loro antico passato e fiduciosi nel futuro. Una città dal carattere tutt’altro che stabile. Il suo fascino consiste proprio nella sua natura irrequieta e irrisolta. Inutile chiederle di somigliare ad altre la cui bellezza è consolidata, composta e appagante. Difatti nessuno si chiede se Venezia è cambiata, perché il problema non si pone. Ci torni dopo vent’anni e più o meno è sempre quella, immobile perché già idealmente perfetta. Palermo non sarà mai così.
Per questo quando incontriamo Elena Piacenza notiamo subito un forte contrasto con la città che da circa due anni l’ha adottata. Alla soglia dei trent’anni ci appare subito ferma, matura e decisa.

Da Calgary a Palermo
Verona, Venezia, Calgary, di nuovo Verona e infine il capoluogo siciliano. Un percorso simile a tanti giovani ricercatori, ma per Elena con una motivazione in più: formarsi, fare esperienza per poi dimostrare e dare tutto nel panorama scientifico italiano.
«Ogni luogo in cui ho vissuto e lavorato mi ha ispirata. Le esperienze maturate hanno ampliato il mio bagaglio culturale e umano. Una costante fonte di ispirazione. Verona vuol dire casa, a Venezia ho imparato lo spirito di adattamento e a Calgary la cordialità e la propensione al dialogo», ci spiega Elena. E Palermo? «È la città che tutt’ora mi sorprende per la sua multiculturalità e accoglienza, aspetti che si riflettono sull’apertura mentale e interdisciplinarietà che si respira in Università». Qui all’Università, Elena, che da poco è diventata ricercatrice, studia nanomateriali, compatibili con i tessuti biologici, che possano prevenire la contaminazione da impianto.
Una ricerca multidisciplinare e trasversale. Dove la chimica, la medicina e la bioingegneria si mescolano. Un po’ come lei che dopo la laurea triennale in biotecnologie a Verona ha conseguito la specialistica in scienze e tecnologie dei bio e nanomateriali a Venezia, per poi ottenere il dottorato in biofisica chimica in Canada.
«Grazie a queste esperienze sono riuscita a sviluppare le capacità per avere una visione ampia dei problemi da affrontare e cercare di individuare strategie congrue per una loro possibile risoluzione».

Una nuova famiglia
Quando siamo nel suo laboratorio non ci colpisce però la sua ricerca ma il suo mondo. Elena lavora, infatti, con altri ragazzi. Hanno un piccolo studio dove trascorrono le giornate a leggere paper, pensare a una nuova linea di ricerca e nel commentare i risultati degli esperimenti. Potrebbe sembrare, a primo sguardo, un ambiente piccolo, stretto e non adatto per lavorare con serenità e tranquillità ma non è così. Vedendoli insieme sembra più grande, allegria e serenità si fondono al rigore e alla dedizione scientifica.
Siamo abituati di solito a pensare che, soprattutto nel mondo della ricerca, possa essere difficile instaurare un’amicizia tra i banchi di laboratorio. Invidia, voglia di emergere, competizione possono, a volte, essere quei granelli che rendono l’ingranaggio dell’amicizia sul posto di lavoro mal funzionante. Ma qui non è così, i ragazzi si muovono nell’informalità e nel bisogno di aiutarsi reciprocamente. La loro è una vera è proprio comunità che alterna risate ad analisi di vetrini, commenti sul cibo ordinato per pranzo alla preparazione della presentazione per il prossimo meeting. «Non solo dei colleghi o dei semplici amici ma sono qualcosa di più. Una famiglia. Quando sono arrivata a Palermo ero sola con il mio ragazzo. Mi sentivo un po’ spaesata ma mi hanno fatto sentire subito accettata e soprattutto sono diventati parte integrante della mia vita», ci racconta Elena. Un rapporto solido che ogni giorno si arricchisce del vissuto insieme. Dal tavolo da lavoro a quello del ristorante per concludere le giornate il passo è breve e malgrado tutte le differenze che ci sono, tutti uniti nella voglia di ridere e di divertirsi e il gusto difficile di non prendersi mai sul serio.

Finalmente grande
Già, la famiglia, quando si è giovani e si intraprende la via della ricerca spesso si è costretti ad andare a lavorare fuori, lontani dai propri cari. Sì, oggi abbiamo Zoom e non le cabine con i gettoni e le cartoline. Voli low-cost e non più le corriere a vapore ma la distanza, con i propri cari, anche quando si è giovani, rimane sempre grande. Ma alcune volte, come diceva Modugno, la lontananza può spegnere i fuochi piccoli. Ma accende quelli grandi. Ci da soprattutto quella possibilità di farci osservare con occhiali diversi, ci spoglia delle vesti dell’abitudine e ci fa apparire per quello che siamo diventati. Così è avvenuto anche a Elena. Dopo qualche mese, i genitori sono venuti a trovarla a Palermo e lì, di fronte al Teatro marmoreo, guardando la loro giovane figlia si sono accorti che quella ragazza partita per Venezia, emigrata a Calgary e infine stabilitasi a Palermo è diventata una donna matura, pronta a percorre la propria strada. Sicura delle proprie idee, delle proprie scelte e orgogliosa della nuova famiglia siciliana. Certo, Elena rappresenta una delle storie di ricercatori che hanno deciso e hanno voluto fortemente fare ritorno nel nostro paese e per questo è opportuno ancora di più soffermarsi e pensare di quanta Italia futura stiamo perdendo. Quante idee, quanta cultura, quanta ricerca. Il progresso scientifico non si alimenta senza ricerca.
Condividi sui social
Ricerca il volto
In quale punto della città è affissa una di queste foto? Trovala e condividila sui social #humansofresearch